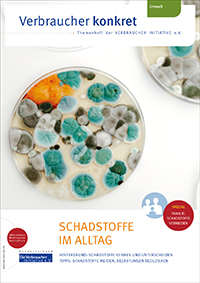

Neues Themenheft der VERBRAUCHER INITIATIVE gibt Orientierung
Berlin, 11. Mai 2023. Ob wir wollen oder nicht: im Alltag kommen wir permanent mit Schadstoffen und Umweltgiften in Kontakt. Über Atmung, Ernährung und Hautkontakt können sie in den Körper gelangen und dort unter Umständen Gesundheitsschäden verursachen. Wie Verbraucher/innen tagtägliche Belastungen reduzieren können, hat die VERBRAUCHER INITIATIVE zusammengefasst.
Schadstoffe befinden sich nahezu überall in der Umwelt. Wie sehr ein Mensch davon belastet ist, hängt von zahlreichen Faktoren ab, insbesondere Lebensstil, Ernährungsweise, Wohnstandort und die Art der Berufstätigkeit. Auch das Alter spielt eine entscheidende Rolle. So gelten Babys, Kinder und ältere Menschen als in besonderer Weise durch Schadstoffe gefährdet. Kinder deshalb, weil sie im Verhältnis zur Körpergröße, häufigerer Atemzüge sowie aufgrund ihres alterstypischen Verhaltens (z. B. Dinge in den Mund nehmen) mit einer größeren Menge Schadstoffen in Kontakt kommen. Bei älteren Menschen hingegen haben sich im Laufe des Lebens bereits mehr Schadstoffe im Körper abgelagert.
„In dieser Welt ist es leider unmöglich, Schadstoffe gänzlich zu vermeiden“, bringt es Fachreferentin Miriam Bätzing auf den Punkt. Verdächtige und erwiesen schädliche Stoffe und Stoffgemische seien einfach zu verbreitet, mögliche (Wechsel-)Wirkungen oft nicht ausreichend untersucht. „Die gute Nachricht lautet aber: fast jeder kann seine tägliche Schadstoffaufnahme reduzieren“, so die Referentin weiter. Schon kleine Verhaltensänderungen im Alltag könnten helfen.
„Die wichtigsten Stellschrauben liegen in den Bereichen Ernährung, Hautpflege und Innenraumgestaltung“, so Bätzing. Wer beispielsweise auf frische und unverarbeitete Produkte in Bio-Qualität setze, könne die Aufnahme von Pestiziden und Schadstoffen aus Fertigungsprozessen deutlich senken. Bei Hautpflegeprodukten sei Naturkosmetik oft die bessere Wahl. Generell gelte dabei „weniger ist mehr“. Auch in Wohninnenräumen lassen sich fast immer Schadstoffbelastungen reduzieren, z. B. durch Verwendung unbedenklicher Reinigungsmittel und Farben. „Es mag banal klingen, aber regelmäßiges Lüften ist das A und O für die Luftraumqualität“, betont die Referentin besonders.
Mit welchen Maßnahmen Verbraucher/innen den Schadstoffkontakt im Alltag reduzieren können, haben wir in der neuen Ausgabe „Schadstoffe im Alltag“ der Themenheftreihe der VERBRAUCHER INITIATIVE zusammengefasst. Die 16-seitige Broschüre kann für 2,00 Euro (zzgl. Versand) unter www.verbraucher.com bestellt oder heruntergeladen werden.
Die VERBRAUCHER INITIATIVE e.V. ist der 1985 gegründete Bundesverband kritischer Verbraucherinnen und Verbraucher. Schwerpunkt ist die ökologische, gesundheitliche und soziale Verbraucherarbeit.
Kontakt
Die VERBRAUCHER INITIATIVE e.V.
Georg Abel
Berliner Allee 105
13088 Berlin
030 53 60 73 41
030 53 60 73 45

https://www.verbraucher.org
Die Bildrechte liegen bei dem Verfasser der Mitteilung.